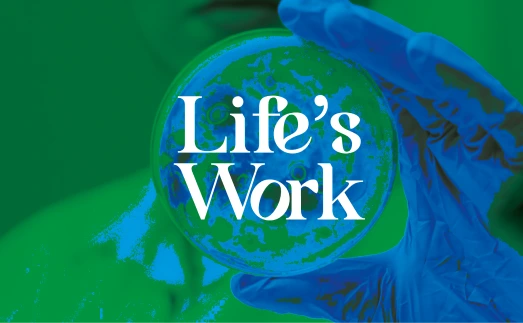

See our work done for the
planet and its people.
Brand identity
Campaigns
Digital
Websites
Purpose
Type:
Area:
Campaign to promote India’s first
toll-free cleft care number from Smiletrain.
Zodiac Black: Healthy Is Beautiful
Cause marketing for Preethi Kitchen
Appliances addressing nutrient deficiency in India.
Preethi Pragya: Hunger For Learning
CSR initiative celebrating and supporting
children with a hunger for learning.

World Soil Day: 3-6-5 on all 365 days
On-ground school activation by Butterfly Kitchen Appliances educating children on soil protection.

Rajasthani Assn: Rajasthani-Tamil Seva Awards
Brand design for a social award instituted to honour people of good will in Tamil Nadu.

Butterfly Onam: From Kerala With Love
An social initiative to celebrate the true yet forgotten spirit of Onam
BRF: Life's Work
Brand Positioning and brand identity for Bioscience Research Foundations.

Butterfly Diwali: Beejpataka
A one-of-a-kind Diwali gift box to build brand relevance among stake holders.




